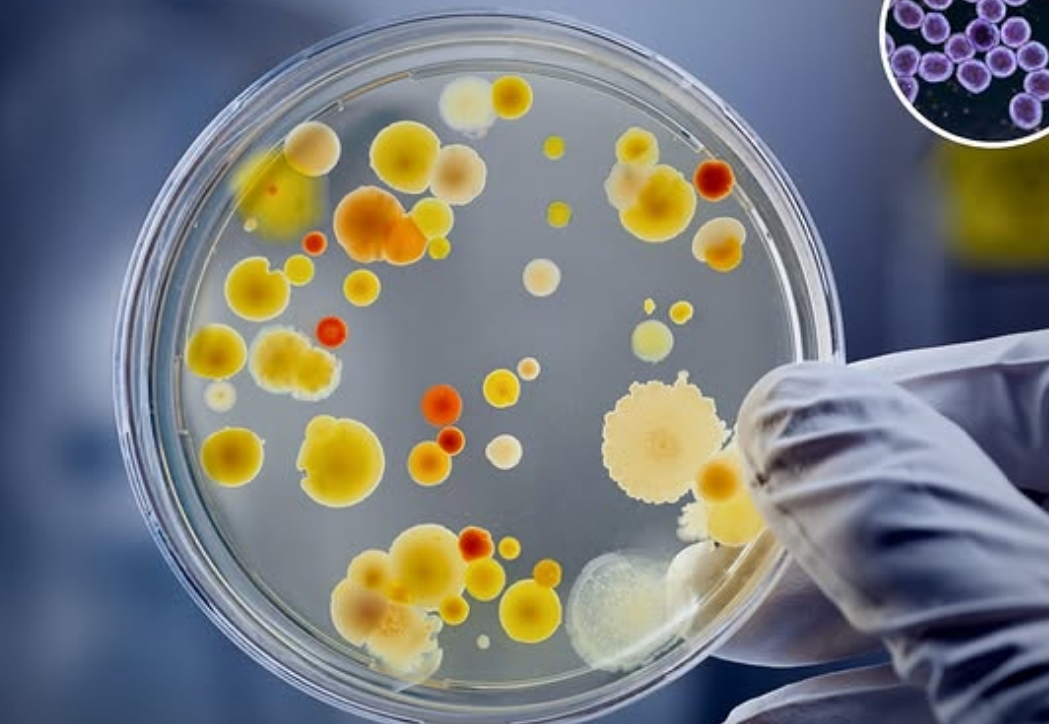
Ingredientes que solo funcionan juntos

Un antiguo remedio del siglo IX sigue funcionando hoy en día
La Chispa trae una interesante noticia de que un antiguo remedio del siglo IX sigue siendo eficaz hoy en día. Esto demuestra que las antiguas culturas tenían amplios conocimientos sobre hierbas y sus funciones médicas. Una ‘poción’ del siglo IX, hecha de cebolla, ajo, vino y bilis de vaca, fue estudiada por científicos y descubrieron que podría matar hasta el 90% del SARM (una super bacteria) la cual es resistente a antibióticos modernos.
Según Science Alert, investigadores de la Universidad de Nottingham y de la Universidad de Warwick replicaron la receta con precisión y la probaron contra biofilms SARM, los cuales son conocidos por su alta resistencia a tratamientos convencionales. Sorprendentemente, el brebaje fue más eficaz que algunos antibióticos actuales, tanto en cultivos de laboratorio como en modelos de heridas en ratones.
¿Qué es el Salve de Ojo Calvo?
El brebaje en cuestión se conoce como Salve de Ojo Calvo, una receta ancestral que se encuentra en el texto médico anglosajón “Libro de Sanguijuelas Calvas”. Este libro representa una de las pocas ventanas que tenemos hacia la medicina sinérgica de la Edad Media.

Ingredientes que solo funcionan juntos
El aspecto más impresionante de este antiguo remedio del siglo IX es que sus ingredientes —cebolla, ajo, vino y bilis de vaca— solo funcionan cuando se combinan. Por separado, ninguno tiene el mismo efecto antimicrobiano. Esto sugiere que los curanderos medievales poseían una comprensión notablemente avanzada sobre combinaciones de plantas y elementos, algo que en la actualidad se estudia como medicina sinérgica.
Este enfoque ancestral tiene paralelismos con prácticas modernas como la fitoterapia y la medicina funcional. En efecto, un antiguo remedio del siglo IX podría abrir caminos para desarrollar tratamientos naturales eficaces contra bacterias resistentes.
Sabiduría ancestral con respaldo moderno
El redescubrimiento de esta fórmula ha motivado investigaciones adicionales sobre otros remedios históricos que podrían estar ocultando propiedades medicinales olvidadas. Además, este hallazgo representa una oportunidad para reconsiderar el valor del conocimiento tradicional dentro de la medicina científica actual.
En tiempos donde la resistencia a los antibióticos en aumento es una preocupación global. Volver a mirar hacia los remedios naturales olvidados puede ser no solo prudente, sino necesario.
